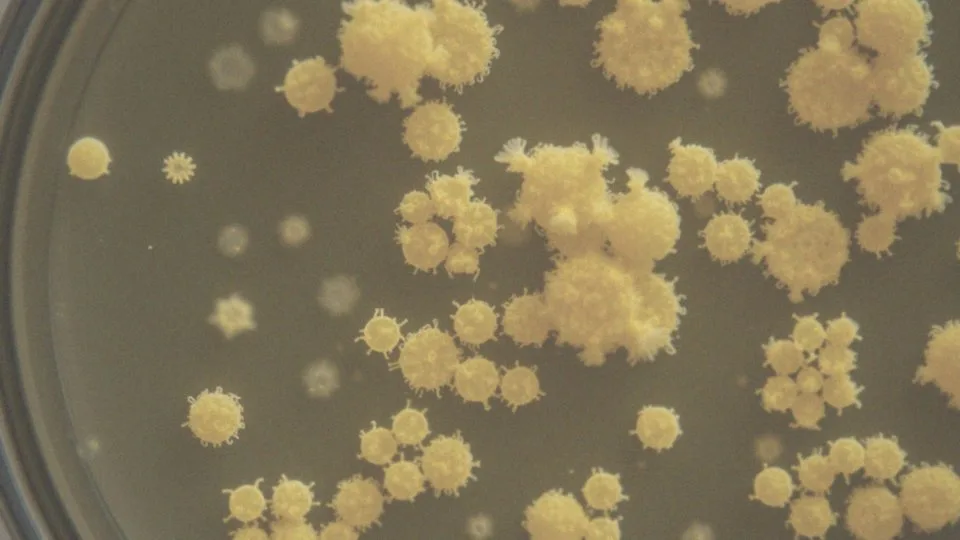
Jakie bakterie są odpowiedzialne za produkcję siarkowodoru?

Spis treści
Co to są gazy o zapachu zgniłych jaj?
Gazy o zapachu zgniłych jaj to specyficzny rodzaj gazów jelitowych, które charakteryzują się bardzo nieprzyjemnym aromatem. Ich powstawanie jest bezpośrednio związane z obecnością siarkowodoru (H2S), wynikającego z procesów fermentacyjnych zachodzących w naszym układzie pokarmowym. Te gazy składają się z wielu składników, takich jak:
- azot,
- tlen,
- dwutlenek węgla,
- wodór,
- metan,
- siarkowodor.
Podczas trawienia niektórych pokarmów bakterie w jelitach produkują ten związek chemiczny, a jego produkcja wzrasta szczególnie po spożyciu żywności bogatej w siarkę, takiej jak:
- cebula,
- czosnek,
- kapusta,
- brokuły,
- jaja.
Ponadto, stan zwany zespołem przerostu flory bakteryjnej jelita cienkiego (SIBO) sprzyja zwiększonej produkcji tych gazów. Nieprzyjemny zapach może być także sygnałem różnych problemów zdrowotnych, takich jak nietolerancje pokarmowe czy dysbioza jelitowa. Aby zmniejszyć ich występowanie, warto ograniczyć spożycie pokarmów bogatych w siarkę. Dobrym pomysłem jest również wzbogacenie diety o produkty, które wspierają trawienie. Zrównoważona dieta oraz probiotyki mają pozytywny wpływ na zdrową florę bakteryjną w jelitach, co w efekcie prowadzi do mniejszej produkcji nieprzyjemnych gazów.
Dlaczego gazy jelitowe mają zapach zgniłych jaj?
Gazy jelitowe często przypominają zapach zgniłych jaj, a jest to efektem obecności siarkowodoru (H₂S), który tworzy się podczas procesu trawienia. Powstawanie tego związku chemicznego jest wynikiem fermentacji bakteryjnej, szczególnie w sytuacji, gdy aminokwasy siarkowe w białkach są rozkładane.
Bakterie, takie jak Bacteroides i Clostridium, zajmują się metabolizowaniem tych aminokwasów, co prowadzi do uwolnienia siarkowodoru, wywołując specyficzny aromat. Spożycie niektórych produktów, takich jak:
- mięso,
- jaja,
- cebula,
- czosnek,
może nasilać ten proces. W określonych warunkach, mikroflora jelitowa ma tendencję do nadprodukcji siarkowodoru, co jest szczególnie widoczne w przypadku zaburzeń, takich jak SIBO.
Aby zminimalizować wydzielanie gazów o nieprzyjemnym zapachu, kluczowe jest przestrzeganie zrównoważonej diety. Wprowadzenie probiotyków może również przynieść korzyści. Utrzymanie zdrowej mikroflory jelitowej odgrywa istotną rolę w skutecznym radzeniu sobie z tym problemem.
Co powoduje powstawanie siarkowodoru w jelitach?
Siarkowodór w jelitach powstaje dzięki mikroorganizmom, które rozkładają białka z aminokwasami siarkowymi, takimi jak:
- metionina,
- cysteina.
Zjawisko to szczególnie intensyfikuje się po spożyciu posiłków bogatych w białko, zwłaszcza czerwonego mięsa. Bakterie z grup Bacteroides i Clostridium metabolizują te aminokwasy, wytwarzając siarkowodór jako jeden z produktów ubocznych. W zdrowym układzie trawiennym jego produkcja jest na ogół utrzymywana w ryzach, jednak nadmiar białka oraz nieodpowiednia dieta mogą prowadzić do jej zwiększenia.
Aby ograniczyć stężenie siarkowodoru w jelitach, warto zmniejszyć spożycie:
- czerwonego mięsa,
- pokarmów bogatych w siarkę, jak:
- cebula,
- czosnek.
Nasze nawyki żywieniowe mają ogromny wpływ na mikroflorę jelitową, która z kolei oddziałuje na wytwarzanie gazów oraz ich zapach. Zdrowa mikroflora sprzyja zrównoważonemu metabolizmowi, co rezultuje w mniejszej produkcji siarkowodoru, a tym samym także w mniej nieprzyjemnym zapachu gazów. Dlatego istotne jest dążenie do zróżnicowanej diety i wzbogacanie jej o probiotyki, co będzie wsparciem dla zdrowia jelit oraz pomoże w redukcji problemów z nieprzyjemnym zapachem.
Jakie bakterie są odpowiedzialne za produkcję siarkowodoru?
Produkcja siarkowodoru w jelitach wynika z aktywności specjalnych bakterii, które uczestniczą w procesach fermentacyjnych. Wśród nich szczególnie istotne są bakterie z rodzaju Desulfovibrio oraz grupa Bacteroides. Te mikroorganizmy zajmują się rozkładem aminokwasów siarkowych, takich jak metionina i cysteina.
Kiedy dieta obfituje w białko i produkty zawierające siarkę, mikroflora jelitowa ma tendencję do intensyfikacji produkcji siarkowodoru. Spożywając pokarmy takie jak:
- jaja,
- cebula,
- czosnek,
- czerwone mięso,
bakterie metabolizują białka, co prowadzi do uwolnienia siarkowodoru o charakterystycznym zapachu oraz innych gazów. Kluczowe jest zrozumienie interakcji między mikroorganizmami a dietą. Przykładowo, zdrowa mikroflora jelitowa ma zdolność do kontrolowania ilości produkowanego siarkowodoru. Natomiast nierównowaga w diecie, a także problemy zdrowotne, takie jak SIBO, mogą spowodować znaczący wzrost jego stężenia. Poznanie roli różnych bakterii w wytwarzaniu siarkowodoru jest istotne, ponieważ pomaga w efektywnym radzeniu sobie z nieprzyjemnymi gazami jelitowymi.
Jak fermentacja bakteryjna wpływa na powstawanie gazów?

Fermentacja bakteryjna ma kluczowe znaczenie w powstawaniu gazów jelitowych, w szczególności siarkowodoru, który potrafi być niezwykle uciążliwy dla naszego nosa. Kiedy niestrawione resztki pokarmowe, takie jak błonnik czy niektóre cukry, docierają do jelit, bakterie zaczynają proces ich rozkładu. To zjawisko ściśle wiąże się z mikroflorą jelitową i prowadzi do wytwarzania różnorodnych gazów, a wśród nich:
- metanu,
- wodoru,
- dwutlenku węgla.
Bakterie z grupy Bacteroides oraz Clostridium są odpowiedzialne za fermentację aminokwasów siarkowych, co skutkuje pojawieniem się siarkowodoru, znanego z charakterystycznego zapachu zgniłych jaj. Warto zwrócić uwagę, że jedzenie bogate w białko, w tym te zawierające metioninę i cysteinę, wpływa na zwiększoną produkcję tego gazu.
Dodatkowo, zaburzenia równowagi w mikroflorze jelitowej, takie jak zespół przerostu flory bakteryjnej jelita cienkiego (SIBO), mogą prowadzić do nadmiernej produkcji siarkowodoru oraz innych nieprzyjemnych substancji. Zmiany w diecie, na przykład ograniczenie pokarmów bogatych w siarkę, takich jak cebula czy czosnek, mogą znacząco pomóc w złagodzeniu problemu nadmiernych gazów. Dostosowanie spożycia białka również jest istotne.
Warto także wprowadzić probiotyki oraz stawiać na zrównoważoną dietę, co wspiera zdrową mikroflorę jelitową. Konsekwentne dbanie o te aspekty prowadzi do mniejszej produkcji nieprzyjemnych zapachów oraz poprawy ogólnego samopoczucia. Zrównoważona fermentacja bakteryjna w jelitach jest kluczowa dla komfortu i zdrowia całego układu pokarmowego.
Jakie pokarmy powodują gazy o zapachu zgniłych jaj?
Niektóre pokarmy mogą powodować powstawanie gazów, których zapach często przypomina woń zgniłych jaj. Zazwyczaj są to produkty bogate w białko oraz różnorodne związki siarki. Przyjrzyjmy się kilku z nich:
- Czerwone mięso – Konsumpcja wołowiny i wieprzowiny przyczynia się do wzrostu siarkowodoru w organizmie. Białka zawarte w mięsie, w trakcie trawienia, mogą generować nieprzyjemne gazy.
- Jaja – Te pyszne źródła białka zawierają aminokwasy siarkowe, które w procesie fermentacji w jelitach przemieniają się w siarkowodór, co prowadzi do charakterystycznego zapachu.
- Warzywa strączkowe – Takie jak fasola, groch, soczewica, ale także cebula czy czosnek, zawierają substancje siarkowe, co może skutkować wydzielaniem gazów o nieprzyjemnym odorze.
- Niektóre warzywa – Warzywa krzyżowe, w tym brokuły, kapusta oraz brukselka, są znane ze swojej zdolności do wytwarzania siarkowodoru, szczególnie u osób z wrażliwym układem pokarmowym.
- Produkty z siarczynami – Różne przetworzone jedzenie, które wykorzystuje siarczyny jako konserwanty, także mogą wpływać na wydzielanie nieprzyjemnych gazów.
Wszystkie te produkty oddziałują na zapach gazów jelitowych w wyniku procesów trawiennych. Odpowiedzialne za to bakterie rozkładają białka, emitując siarkowodór, co pogarsza sytuację. W przypadku wystąpienia pewnych problemów zdrowotnych, takich jak SIBO, może dochodzić do nadmiernej produkcji takich gazów. Warto zatem monitorować swoją dietę i rozważyć wprowadzenie stosownych zmian, które mogą przynieść ulgę w tej kwestii.
Jakie są inne przyczyny nieprzyjemnych zapachów w gazach jelitowych?
Nieprzyjemne zapachy gazów jelitowych wynikają z różnych czynników wpływających na ich chemiczny skład. Oprócz siarkowodoru, który przypomina woń zgniłych jaj, istotną rolę odgrywają także inne substancje, takie jak:
- merkaptany,
- amoniak,
- indol,
- skatol.
Te związki powstają, gdy bakterie w naszych jelitach rozkładają pozostałości pokarmowe. Problemy z trawieniem, w tym nietolerancje pokarmowe, mają tutaj znaczenie. Osoby z nietolerancją laktozy, na przykład, mogą doświadczać nadmiaru gazów, ponieważ ich organizm ma trudności z trawieniem tego składnika. Podobnie, nietolerancja glutenu często prowadzi do dyskomfortu w układzie pokarmowym oraz zwiększonej produkcji gazów o nieprzyjemnym zapachu. Mikroflora jelitowa odgrywa kluczową rolę w tym procesie. Gdy jej równowaga zostaje zakłócona, na przykład przez dysbiozę czy zespół przerostu flory bakteryjnej jelita cienkiego (SIBO), może to prowadzić do nadmiernej produkcji gazów. Bakterie odpowiedzialne za fermentację białek i węglowodanów wytwarzają różnorodne gazy, co nasila problem nieprzyjemnych aromatów.
Dodatkowo, spożycie pokarmów bogatych w siarkę, takich jak:
- cebula,
- czosnek,
- czerwone mięso,
może pogorszyć objawy. Dlatego warto zastanowić się nad swoją dietą i wprowadzić zmiany, które pozwolą poprawić trawienie oraz ograniczyć wydzielanie uciążliwych gazów. Na przykład, można ograniczyć białko i żywność bogatą w siarkę, a także wprowadzić probiotyki, które wspierają zdrową mikroflorę jelitową.
Jakie są objawy związane z nadmiarem gazów w jelitach?

Nadmierna ilość gazów w jelitach objawia się różnymi dolegliwościami, takimi jak:
- wzdęcia,
- uczucie przepełnienia,
- ból brzucha.
Te symptomy mogą powodować spory dyskomfort. Osoby borykające się z tym problemem często zwracają uwagę na:
- burczenie w brzuchu,
- odbijanie,
- intensywne wydzielanie gazów.
Czasami może to prowadzić do dodatkowych dolegliwości, takich jak:
- uczucie ucisku,
- bóle.
Należy także zauważyć, że nieprzyjemny zapach gazów często jest wynikiem diety bogatej w siarkę. Jeśli pojawiają się zaparcia, objawy te mogą się nasilać, co sprzyja jeszcze większemu dyskomfortowi. Warto zatem przyjrzeć się swojej diecie i trybowi życia, aby odkryć potencjalne źródła problemów trawiennych. Regularne śledzenie stanu zdrowia oraz skonsultowanie się z lekarzem może znacząco pomóc w identyfikacji przyczyn nadmiernych gazów.
Jakie problemy zdrowotne mogą być związane z gazami jelitowymi?
Problemy zdrowotne związane z gazami jelitowymi to temat, który dotyczy wielu osób. Wśród najczęstszych schorzeń znajdują się:
- zespół jelita drażliwego (IBS),
- przerost bakterii w jelicie cienkim (SIBO),
- naturalne nietolerancje pokarmowe, takie jak nietolerancja laktozy.
Zespół jelita drażliwego często objawia się:
- wzdęciami,
- bólami brzucha,
- nieprzyjemnym zapachem gazów.
SIBO wiąże się ze zwiększoną produkcją gazów w wyniku nieodpowiedniej fermentacji pokarmów przez bakterie. Dodatkowo, infekcje jelitowe oraz stany zapalne mogą prowadzić do wydzielania gazów o silnym zapachu. Dysbioza, czyli zaburzenia równowagi mikroflory jelitowej, również sprzyja tym problemom.
Kluczowe w tej sytuacji jest świadome monitorowanie diety, co pozwala na zidentyfikowanie pokarmów, które mogą zaostrzać objawy. Regularne działania na rzecz zdrowia układu pokarmowego są niezwykle cenne i mogą skutecznie zapobiegać występowaniu nieprzyjemnych problemów z gazami jelitowymi.
Co to jest SIBO i jak wpływa na gazy jelitowe?
SIBO, czyli zespół przerostu flory bakteryjnej jelita cienkiego, oznacza stan, w którym w tym odcinku przewodu pokarmowego występuje zbyt duża ilość bakterii. Zazwyczaj bowiem mikroorganizmy te zamieszkują jelito grube. Przesyt bakterii w jelicie cienkim prowadzi do nadmiernej fermentacji pokarmów, co z kolei skutkuje produkcją gazów, wzdęciami oraz problemami z trawieniem.
Osoby z SIBO często odczuwają dyskomfort, a także doświadczają nieprzyjemnych zapachów wydobywających się z gazów, co w znacznym stopniu wpływa na ich codzienne funkcjonowanie. Szczególnie niemiły zapach związany jest z siarkowodorem, który przypomina woń zgniłych jajek. Bakterie te fermentują białka i inne składniki odżywcze, co prowadzi do wydzielania gazów o przykrym aromacie.
Dlatego kluczowe jest znalezienie skutecznych metod na zarządzanie SIBO, aby poprawić jakość życia. Osoby z problemem powinny rozważyć modyfikacje w swojej diecie, takie jak:
- ograniczenie pokarmów bogatych w siarkę, jak cebula czy czosnek,
- zmniejszenie ilości białek zwierzęcych,
- wprowadzenie probiotyków, które mogą wspierać odbudowę zdrowej mikroflory jelitowej.
Wprowadzenie zmian w diecie może przynieść pozytywne efekty, co z kolei przyczynia się do zmniejszenia produkcji gazów i poprawy ogólnego samopoczucia. Wiedza na temat SIBO umożliwia lepsze zrozumienie jego wpływu na zdrowie jelit oraz sposoby na skuteczne radzenie sobie z nadmierną fermentacją i towarzyszącymi jej nieprzyjemnymi zapachami.
Jak zminimalizować gazy o zapachu zgniłych jaj w diecie?
Aby zredukować nieprzyjemne gazy o charakterystycznym zapachu zgniłych jaj w diecie, warto wprowadzić kilka kluczowych zmian. Po pierwsze, warto ograniczyć spożycie pokarmów, które są bogate w białka oraz związki siarki. Wśród nich wyróżniają się:
- czerwone mięso,
- jaja,
- cebula,
- czosnek,
- brokuły.
Wykreślenie przetworzonych produktów, które zawierają siarczyny, również przyniesie korzyści w postaci mniejszej ilości nieprzyjemnych zapachów. Dodatkowo, ograniczenie pokarmów składających się z aminokwasów siarkowych, takich jak metionina i cysteina, pomoże w obniżeniu stężenia siarkowodoru w jelitach. Ponadto, warto zwiększyć spożycie produktów bogatych w błonnik, co pozytywnie wpłynie na proces trawienia. Włączenie probiotyków do diety to kolejny krok, który może wspierać zdrową florę bakteryjną i przyczynić się do mniejszej produkcji gazów oraz ich nieprzyjemnych zapachów. Również dbanie o odpowiednie nawyki żywieniowe, takie jak spożywanie posiłków w spokojnej atmosferze i staranne przeżuwanie, może przynieść zaskakujące efekty.
Trzeba również unikać napojów gazowanych i żucia gumy, co może przyczynić się do złagodzenia tego problemu. Wprowadzenie tych modyfikacji w diecie i codziennym stylu życia może znacząco poprawić komfort trawienny oraz zmniejszyć występowanie nieprzyjemnych gazów.
Jakie są naturalne sposoby na złagodzenie wzdęć i gazów?
Istnieje wiele naturalnych metod, które mogą pomóc w łagodzeniu wzdęć i gazów, stając się wsparciem w codziennych problemach z trawieniem. Warto sięgnąć po ziołowe napary, jak mięta, rumianek czy imbir – te napoje nie tylko wspierają procesy trawienne, ale również pomagają w relaksacji mięśni jelit, co przyczynia się do zmniejszenia uczucia wzdęcia. Wprowadzenie przypraw, takich jak kmin czy kolendra, ma pozytywny wpływ na mikroflorę jelitową, co przyspiesza trawienie.
- regularna aktywność fizyczna wspomaga perystaltykę jelit oraz ułatwia pozbywanie się gazów,
- unikanie połknięcia powietrza w trakcie posiłków,
- spokojne spożywanie pokarmów zmniejsza wzdęcia,
- regularność wypróżnień zapobiega gromadzeniu się gazów w jelitach,
- zmiany w diecie, w tym ograniczenie produktów bogatych w siarkę, mogą poprawić zapach i ilość wytwarzanych gazów.
Wprowadzenie probiotyków korzystnie wpłynie na równowagę mikroflory jelitowej. Pamiętajmy, aby utrzymywać zrównoważoną dietę oraz unikać potraw, które mogą wywoływać trudności w trawieniu, co jest kluczowym krokiem w łagodzeniu objawów związanych z wzdęciami i gazami.



